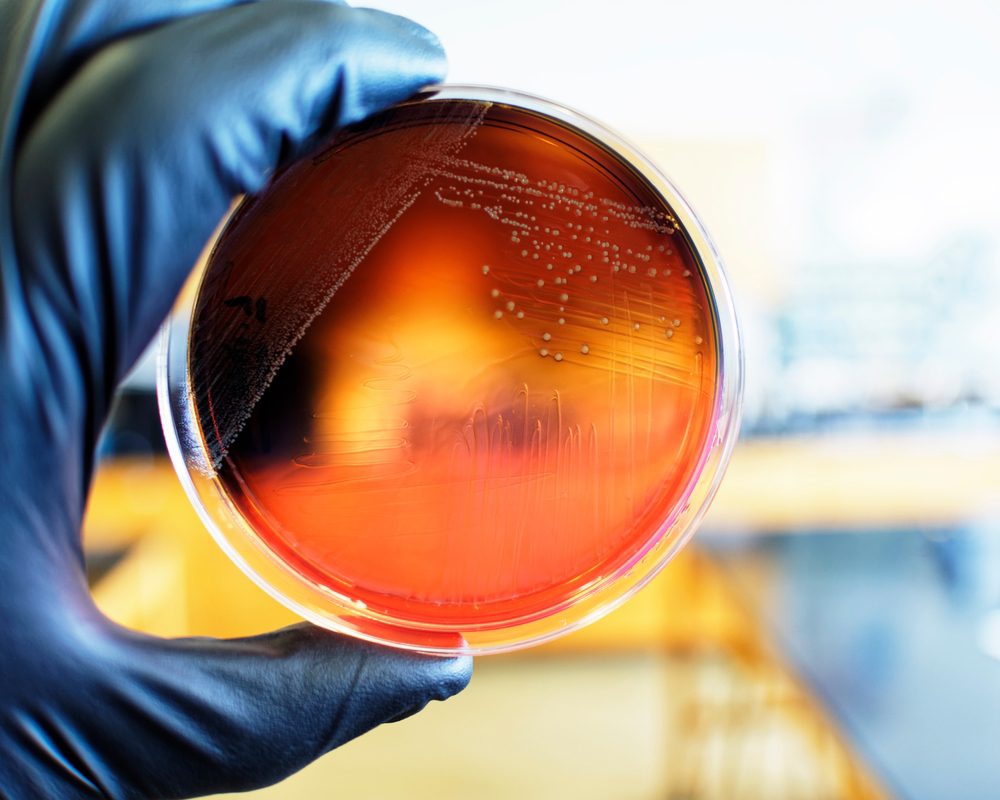

| newfoodmagazine.com ▼ | Past 90 Days | 70 stories | 1 Authors |
Trending Today
Sort By: Latest
| Topic | # Mentions | Topic Reach |
|---|
| Byline | Articles Written | Avg Reach |
|---|---|---|
| 70 | - |

Melt&Marble secures US self-affirmed GRAS status for fermented fat ingredient
12 hours ago - 2026-03-12 01:40:42

Counterfeit wine and prosecco worth £500k seized in NFCU alcohol fraud investigation
12 hours ago - 2026-03-12 01:40:42

European Commission launches AI TraceMap tool to combat food fraud and outbreaks
Yesterday - 2026-03-11 06:10:42

Mondelēz advances sustainable packaging goals with Cadbury Easter range
Yesterday - 2026-03-11 01:10:48

Government launches consultation on statutory guidance to improve allergy safety in schools
1 weeks ago - 2026-03-05 04:50:41

Global food system resilience gaps exposed in new Economist Impact index
2 weeks ago - 2026-03-04 04:20:54

Bezos Centre Conference 2026: "No Plan B" without alternative protein price parity
2 weeks ago - 2026-03-03 08:41:04

FDA upgrades frozen blueberries recall to Class I over listeria concern
2 weeks ago - 2026-02-26 09:50:42

Global chocolate giants unite under TogetherCocoa Foundation to strengthen cocoa supply chain
2 weeks ago - 2026-02-26 04:41:46

Government backs farmers with £345 million productivity and innovation funding
3 weeks ago - 2026-02-25 04:11:23

IUCN and CGIAR unite to accelerate nature-positive global food systems transformation
3 weeks ago - 2026-02-24 08:30:50

University of Maine scientists develop plastic-free packaging using mushroom mycelium
3 weeks ago - 2026-02-23 07:50:47
Unpacking the evolving science of pathogen persistence in food processing environments
3 weeks ago - 2026-02-23 02:30:55
Execution: 0.15 Seconds. 135.57 mb used.







